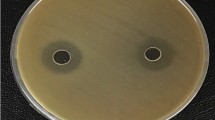

Abstract
We studied a strain of Bacillus isolated from an artisanal tannery in Salta, Argentina. It was identified as Bacillus licheniformis B6 by 16 S phylogenetic analysis and MALDI TOF (GenBank accession code No. KP776730). The synthesis of lipopeptides by B6 and their antibacterial activity against clinical pathogenic strains was analyzed both in the cell-free supernatant (CFS) and in the crude fraction of lipopeptides (LF). Overall, the CFS did not significantly reduce the viability of the studied strains (Staphylococcus aureus 269 and ATCC 43,300, Escherichia coli 4591 and 25,922, Klebsiella sp. 1087 and 1101). However, LF at 9 mg/mL reduced the viability of those pathogenic strains by 2 and 3 log orders compared to those of the control. When the effects of LF and ampicillin were compared, they showed different sensitivity against pathogenic strains. For example, E. coli 4591 was the strain most resistant to ampicillin, requiring 250 mg/mL of antibiotic to achieve the same inhibitory effect as 9 mg/mL of B6 LF. SEM observations of the effect of LF on biofilm formation by E. coli 4591 and Klebsiella sp. 1087 clearly showed that biofilm structures were destabilized, these strains turning into weak biofilm formers. Signals in the CFS and LF corresponding to kurstakin and iturin were identified by MALDI TOF. Interestingly, surfactin was detected, rather than lichenysin, the expected lipopeptide in B. licheniformis species. Signals of bacitracin and fengycins were also found, the latter with a higher number of homologues and relative intensity in the LF than the other lipopeptides. These results show that the lipopeptides synthesized by B. licheniformis B6 have both potential antibacterial and anti-biofilm activity against pathogenic bacteria of health importance.
Highlights
Bacillus licheniformis B6 (Genbank accession code Nº KP776730, isolated from an artisanal tannery) synthesizes lipopeptides with biological activity.
The crude fraction of lipopeptides (LF) had antagonistic action against Staphylococcus aureus 269 and ATCC 43300, Escherichia coli 4591 and 25922, Klebsiella sp. 1087 and 1101.
9 mg/mL of B6 LF were effective to inhibit E. coli 4591, whereas 250 mg/mL of ampicillin were necessary to elicit a similar effect.
SEM observations of the effect of LF on biofilm formation by E. coli 4591 and Klebsiella sp. 1087 clearly showed that biofilm structures were destabilized.
Signals in the LF corresponding to kurstakins and iturin were identified by MALDI TOF; surfactin was detected instead of lichenysin.
Similar content being viewed by others
Avoid common mistakes on your manuscript.
Introduction
Bacillus licheniformis is a Gram-positive thermophilic bacterium. Studies have confirmed that their strains can grow and produce biosurfactants such as lipopeptides under aerobic and anaerobic conditions, and under conditions of high salinity and temperature (Lin et al. 1998). Biosurfactants are amphiphilic metabolites produced by a wide group of bacteria and can be a useful tool for fighting against biofilm-forming bacteria. Their advantages include low toxicity, high biodegradability, good environmental compatibility, high foaming capacity, high selectivity, and stability in extreme environments (Desai and Banat 1997). Lipopeptides are particularly interesting due to their high surface tension activity and antibiotic potential (Bonmatin et al. 2012; Zhao et al. 2017). B. licheniformis is Generally Recognized as Safe (GRAS) by the European Food Safety Authority (FAO 2011; EFSA 2021). Moreover, due to its capacity to control the growth of pathogens, the species has been considered/suggested as an alternative to conventional antibiotics (Ramasubburayan et al. 2014). The lipopeptides synthesized by B. licheniformis, such as lichenysin, iturin, bacitracin, and fengycin, have the potential to inhibit the growth and biofilm formation of human and animal pathogenic bacteria, mainly Gram-positive ones, like Staphylococcus aureus, Listeria monocytogenes, and B. cereus, and some Gram-negative bacteria, including Escherichia coli, Salmonella Typhimurium, and Aeromonas sp.(Cladera-Olivera et al. 2004; Shobharani et al. 2015; Giri et al. 2019; Lin et al. 2020). Antibiotics and commercial drugs are essential to treat and control infections caused by pathogens; however, their misuse has been associated with the emergence and spread of highly resistant strains (WHO, 2018). E. coli, S. aureus, and Klebsiella sp. are among the most drug-resistant pathogenic bacteria, causing nosocomial diseases that call for substantial medical and economic resources (Lautenbach et al. 2001; Newell et al. 2010; WHO 2018). These bacterial genera are characterized by biofilm formation, thus being a matter of major health concern both in hospitals (Donelli and Vuotto 2014) and in the food industry (Van Houdt and Michiels 2010). Biofilms are a common lifestyle of bacterial communities where cells are embedded in a self-produced, highly hydrated matrix composed of common biopolymers like polysaccharides, proteins, and extracellular DNA (Flemming et al. 2016). In biofilms, bacterial cells exhibit increased resistance to antimicrobial agents because the matrix acts as a barrier, and most cells are metabolically inactive. Biofilms produced by multidrug-resistant (MDR) strains in nosocomial infections are of particular medical interest as they pose serious risks to patients and produce high social costs. (Fux et al. 2005). As a result, treatments aimed at preventing or limiting biofilm formation are currently being researched. In this work, we studied a strain of Bacillus isolated from an artisanal tannery (Salta, Argentina) in terms of lipopeptide synthesis, antibacterial activity, and capacity to inhibit the biofilm formation of bacterial pathogens of public health significance according to the last WHO reports (WHO 2018; WHO 2021).
Materials and methods
Bacillus strain growth and maintenance conditions
The strain Bacillus B6 was isolated from an artisanal tannery (Salta, Argentina) and phylogenetically characterized. It was routinely grown at 37 ºC for 24 h in Luria-Bertani (LB) medium without agitation and preserved in vials containing LB broth plus 10% v/v glycerol at -20 °C.
Indicator microorganisms
The clinical strains used as indicator microorganisms were Staphylococcus aureus 269 and ATCC 43,300, Escherichia coli 4591 and 25,922, and Klebsiella sp. 1087 and 1101. All strains were grown in brain-heart infusion broth (BHI, Britania, Argentina) at 37 ºC without a special atmosphere and kept at -20ºC in BHI broth with glycerol (10% v/v). These strains were obtained from Mother and Child Public Hospital of Salta, Pablo Soria Hospital of Jujuy, and American Type Culture Collection (ATCC).
Phylogenetic characterization of Bacillus B6
DNA extraction was carried out with an active culture according to Miller (1972). For the genotypic characterization, the isolate was genetically characterized by analysis of the subunit 16 S of rRNA and sequencing was performed on both strands by the commercial services of Macrogen Inc. (Seoul, Korea). Briefly, intergenic 16-23 S transcribed spacer PCR (ITS-PCR) was carried out using nucleotide single universal strand primers S-D-Bact-0008-a-S-20 (AGAGTTTGATCCTGGCTCAG) and S-D-Bact-1495-a-A-20 (CTACGGCTACCTTGTTACGA) (Daffonchio et al. 1998). The extracted genomic DNA was amplified in a 25-µL reaction mixture containing 0.2 µL Taq polymerase, 2.5 µL 10 X buffer STR, 0.1 µL primer, 17.1 µL PCR water and 5 µL DNA. Amplification consisted of an initial denaturation step at 94 ºC for 5 min, followed by 35 cycles at 94 ºC for 1 min, 50 ºC for 2 min and 72 ºC for 2 min, and a final extension at 72 ºC for 7 min. Control reaction mixtures lacking template DNA were also included in each experiment. The PCR products were separated on 1% (w/v) agarose gel electrophoresis set at 70 volts for 60 min. Gel patterns were visualized with UV by staining with “SYBR safe DNA gel stain (INVITROGEN)”. On-line search for similarity was carried out at GenBank using the BLAST program (http://www.ncbi.nlm.nih.gov).
Microbial identification by UV-MALDI Mass Spectrometry
Bacillus B6 strain was identified by obtaining spectra using MALDI-TOF MS technology (Ultraviolet Matrix Assisted Laser Desorption Ionization Time-of-Flight Mass Spectrometry); the spectra were analyzed with the VITEK® MS database (by Cibic Cepide- Rosario, Argentina). It was used as a complementary method to confirm the identification of this strain.
Preparation of Bacillus cell-free supernatant
The inhibitory effect of B. licheniformis B6 cell-free supernatant (CFS) was evaluated. LB medium was inoculated with a pure culture of B6 and incubated at 37 ºC for 6 days, without agitation. Then, the CFS was obtained by centrifugation (10,000 g for 10 min at 4 ºC) and filter-sterilized (0.22 μm pore-size cellulose acetate membranes). CFS was kept at 4 ºC until further analysis.
Extraction of lipopeptides
Lipopeptide synthesis was analyzed according to Sabaté et al. (2009). Briefly, the CFS was obtained as described above. The lipopeptides were then precipitated by acidification with concentrated HCl; recovered by centrifugation (14,000 g at 4 ºC for 25 min) and finally extracted with methanol, according to Youssef et al. (2004). The solvent was evaporated and the precipitate containing different lipopeptides was dissolved in sterile distilled water (pH 8); the resulting sample was denominated lipopeptide fraction (LF).
MALDI-MS analysis of lipopeptides
Lipopeptides produced by B. licheniformis B6 were identified by UV-MALDI-MS in CFS and LF samples. Spectra were recorded on the MALDI TOF/TOF UltraFlex II (Bruker Daltonics, Bremen, Germany). Mass spectra were acquired in linear positive mode and with LIFT device on MS/MS mode. External mass calibration was performed using β-cyclodextrin (MW 1134) with 9 H-pyrido[3,4b]-indole (norharmane, nHo) as matrix. The matrix signal was used as an additional standard for calibration. Sample solutions were spotted on an MTP 384 target plate polished steel from Bruker Daltonics (Leipzig, Germany). MALDI-MS matrix solutions were prepared with nHo (1 mg/mL) in acetonitrile/water (1:1, v/v). For UV-MALDI-MS experiments, the sandwich method was used according to Nonami et al. (1998); 0.5 mL of matrix solution, 0.5 mL of analyte solution (or suspension) and matrix solution (0.5 ml ox 2) were loaded successively after drying each layer at normal atmosphere and room temperature. The matrix to analyte ratio was 3:1 (v/v) and the matrix and analyte solution loading sequence was: (i) matrix, (ii) analyte, (iii) matrix, (iv) matrix. Desorption/ionization was obtained using the frequency-tripled Nd:YAG laser (355-nm). Experiments were performed using the full range setting for laser firing position in order to select the optimal position for data collection, and then fixing the laser firing position in the sample sweet spots. The laser power was adjusted to obtain high signal-to-noise ratio (S/N) while ensuring minimal fragmentation of the parent ions and each mass spectrum was generated by averaging 100 laser pulses per spot. Spectra were obtained and analyzed with the programs FlexControl and FlexAnalysis, respectively. Experiments were conducted on two spots (duplicate) prepared with each individual sample. In order to check reproducibility of the data, each sample was prepared and measured independently at least on two different days. Thus, our conclusions come from observations of results obtained for each sample, at least 4 times 9 H-yrido[3,4-b]indole (norharmane, nHo) and β-cyclodextrin (cyclomaltoheptaose) were purchased from Sigma-Aldrich Chemical Co. HPLC grade acetonitrile was used. Water of very low conductivity (Milli Q grade) was used.
Minimum inhibitory concentration of ampicillin by the well diffusion assay
The minimum inhibitory concentration (MIC) of ampicillin was determined in a range of 500–0.001 mg/mL against all the indicator strains (Staphylococcus aureus 269 and ATCC 43,300, Escherichia coli 4591 and 25,922, Klebsiella sp. 1087 and 1101), using the well diffusion assay, as described by Audisio et al. (2005). Twenty-two µL of each sample were dropped in 5 mm wells made in MH agar plates inoculated with 107 CFU/mL of the indicator strain. Plates were incubated at 30 °C for 24 h and examined for inhibition halos (mm).
Minimum inhibitory concentration of B6 samples determined by the microplate direct contact assay
The minimal inhibitory concentrations (MIC) of LF and CFS from B. licheniformis B6 against Klebsiella sp. 1087, S. aureus 269 and E. coli 4591 were evaluated. Cells from overnight cultures grown in BHI broth were diluted in peptone water in order to obtain a suspension ca. 103 CFU/mL. The antibacterial effect was analyzed as follows: 96-well microplates were used and different concentrations of LF (2, 4, 9 and 20 mg/ mL) were put in direct contact with suspensions of the indicator strain at a 1/10 ratio at 37 ºC for 2, 4 and 6 h. Viable culturable indicator cells were determined by plate count in duplicate using BHI (1.5% w/v) agar. The plates were incubated at 37 ºC for 24 h (Ibarguren et al. 2010). In addition, the antibacterial activity of the LF was compared with the MIC of ampicillin for each pathogenic strain studied.
Quantification and classification of biofilm formation
The anti-biofilm effect of LF at 9 mg/mL on E. coli (strains 4591 and ATCC 25,922), and Klebsiella sp. (strains 1087 and 1101) was evaluated. Pathogenic strains were grown under static conditions on 24-well polystyrene microtiter plates. In each well, an active pathogenic strain was inoculated in water at pH 8 and in the LF of B6 at a dilution 1:40. The negative control consisted of sterile water at pH 8; B. subtilis subsp. subtilis Mori 2 were used as positive control, since it is a strong biofilm producer strain (Sabaté et al. 2012). Plates were incubated at 30 °C for 24 h. Then, the liquid from the plate was removed, washed three times with sterile distilled water and left to dry in an inverted position for 30 min. Biofilm formation in each well was determined using crystal violet staining (O’Toole and Kolter 1998). The excess of crystal violet was removed with successive rinses with distilled water, and then the stained cells were solubilized with 95% ethanol. Biofilms formed in polystyrene wells were quantified at an absorbance of 595; based on these values, biofilm formation was classified into four categories: Non-forming; weak; moderate and strong (Merritt et al. 1947; Borucki et al. 2003; Stepanović et al. 2004).
Scanning electron microscopy analyses
To observe the anti-biofilm effect of B6 strain by Scanning Electron Microscopy (SEM), slides (1 cm2) were placed in the wells of a culture plate containing dilutions (1:40) of the active pathogenic strain with water pH 8 and LF 9 mg/mL. The plate was incubated at 30 °C for 24 h. Then the slides were recovered, smoothly washed and the formed biofilm was fixed, as mentioned by Torres et al. (2016). Briefly, the samples were treated with glutaraldehyde 2.5% v/v in a 0.1 M phosphate buffer solution of pH 7.2, for 24 h at 4 °C. Then, an alcohol dehydration was performed using 10%, 30%, 50%, 70%, 96% and 100% of ethanol 96° (v/v); the samples were left in contact with each alcoholic solution for 15 min, except for the 100% concentration, in which the samples were left up to a complete drying. Finally, the dehydrated samples were metallized and observed at 15 kV on a Joel JMS 6480 LV computer (Scanning Electron Microscopy and Microanalysis by X-ray Scattering), LASEM laboratory—INIQUI (Laboratory of Electron Microscopy and Microanalysis).
Statistical analysis
The antibacterial and antibiofilm activity assays against pathogenic bacteria, both from the CFS and LF of B. licheniformis B6, were carried out in triplicate. Average values and standard deviations represent the outcomes of these effects. The data were analyzed by the Infostat 2017 statistical program and the result of each treatment was informed as the average value +- standard deviation.
Results
Bacterial identification by phylogenetic and UV-MALDI Mass Spectrometry methods
Analysis of the 16 S rRNA subunit revealed that strain B6 presents 98% homology with known strains of Bacillus licheniformis of the GenBank database, according to the BLAST program. The nucleotide frequency was deposited at GenBank under KP776730 accession code number. The genetic homology of B. licheniformis B6 with related species can be observed in the phylogenetic tree constructed using the neighbor-joining method (Fig. 1). The phylogenetic distance between this strain and the pathogenic species B. cereus is remarkable. The identity of this strain was also confirmed by MALDI TOF assay, using the VITEK database (http://go.biomerieux.com/vitek-v3).
Inhibitory activity of the cell-free supernatant (CFS) and the lipopeptide fraction (LF)
As shown in Fig. 2a, Staphylococcus aureus 269 was resistant to the inhibitory effect of CFS of B6 and no viability reduction was observed using the direct content technique. However, this strain was sensitive to partially purified B6 lipopeptides, since LF at 9 mg/mL reduced viability by 2 orders of magnitude, whereas LF at 20 mg/mL was more active, inhibiting growth by 2.5 orders of magnitude. On the other hand, CFS showed an inhibitory effect on Klebsiella sp. 1087, reducing its viability by 1 order in relation to the control. However, this inhibitory effect was more marked when the pathogen grew in contact with 9 and 20 mg/mL of the LF, with reductions of 2 and 3 orders of magnitude, respectively, compared to the control (Fig. 2b). Similarly, CFS reduced growth of E. coli 4591 by 1 logarithmic order and LF at 9 mg/mL and 20 mg/mL reduced viability to around 1.5 and 2 logarithmic orders compared to the control (Fig. 2c). Finally, LF at 2 and 4 mg/mL showed no significant inhibitory activity against the evaluated pathogenic strains. Since the antibacterial activity of LF at 9 and 20 mg/mL was similar, further assays for viability inhibition and biofilm formation of pathogenic bacteria were performed with LF at 9 mg/mL concentration.
Antibacterial effect of SLC and FLs of B. licheniformis B6 against: (A) S. aureus 269, (B) E. coli 4591 and (C) Klebsiella sp. 1087. Culture medium control (square, continuous line); H2O at pH 8 (circle, continuous line); CFS (triangle, continuous line); LF 20 mg/mL (open square, dotted line); LF 9.0 mg/mL (open triangle, dotted line); LF 4.0 mg/mL (open rhombus, dotted line); LF 2.0 mg/mL (open circle, dotted line)
Comparison of inhibitory effect of LF with ampicillin MIC
The MIC of ampicillin was determined for further use as a positive control of inhibition and compared with LF MIC (at a final concentration of 9 mg/mL) against E. coli 4591, E. coli ATCC 25,922, Klebsiella 1101, Klebsiella 1087, S. aureus 269, and S. aureus ATCC 43,300 (Fig. 3). As shown in Fig. 3, the sensitivity of E. coli strains differed between LF and ampicillin. After 6 h of contact, the viability of E. coli ATCC 25,922 incubated with LF was reduced by 2 orders, whereas its growth fell by 3 logarithmic orders in the presence of ampicillin (0.075 mg/mL), compared to that of the control (Fig. 3a). On the other hand, E. coli 4591 was more resistant to the synthetic antibiotic, since a 250 mg/mL concentration was required to produce the same inhibitory effect (i.e., a viability reduction of about 1.5 logarithmic orders) as that of 9 mg/mL of LF (Fig. 3b).
Direct contact of pathogenic strains with LF 9 mg/mL and ampicillin MIC. Dotted line- circles (Control); Continuous line-Squares (LF 9 mg/mL); continuous line- Triangles (ampicillin). The ampicillin MIC for pathogenic strains was determined and used as a positive inhibition, E. coli 4591 MIC 250 mg/mL; E. coli ATCC 25,922 MIC 0.075 mg/mL; Klebsiella 1101 MIC 1.5 mg/mL; Klebsiella 1087 MIC 1.5 mg/mL; S. aureus 269 0.01 mg/mL; S. aureus ATCC 43,300 MIC 0.025 mg/mL
On the other hand, both Klebsiella sp. strains exhibited a similar behavior in contact with both LF and ampicillin (Fig. 3c-d). After 6 h of contact, LF reduced the viability of both strains to about 2 logarithmic orders compared to that of the control, whereas ampicillin MIC (1.5 mg/mL) reduced it by 4 logarithmic orders. These results suggest a bacteriostatic activity of lipopeptides and a bactericidal effect of the synthetic antibiotic against these pathogenic strains.
Finally, both strains of S. aureus showed a different response to the lipopeptides. S. aureus 269 was sensitive to LF and to ampicillin (0.01 mg/mL), with a reduction of its viability of 1 and 2 logarithmic orders, respectively, compared to that of the control (Fig. 3e). However, S. aureus ATCC 43,300 was more resistant to the activity of LF, since its growth was similar to that of the control. In turn, MIC of ampicillin (0.025 mg/mL) reduced S. aureus ATCC 43,300 viability by 3 logarithmic orders at 6 h of contact (Fig. 3f).
Anti-biofilm effect of lipopeptides produced by B. licheniformis B6
The LF at a final concentration of 9 mg/mL was studied in terms of its capacity to affect biofilm formation of E. coli and Klebsiella strains (Fig. 4). E. coli control cells showed a high intrinsic ability to form biofilm (Fig. 4a), whereas, in the presence of LF, lack of staining with crystal violet in the well showed that lipopeptides affected the biofilm formation of E. coli strain. The biofilm structure of E. coli 4591 was observed under SEM, both in the control and treatment with MIC of LF. In the control, abundant cell communities embedded in a dense matrix were observed, with the mature biofilm structure being adhered to the glass surface (Fig. 4a). In contact with LF, E. coli 4591 showed no structures resembling a biofilm, but only scarce cells attached to the glass (Fig. 4a). Furthermore, LF showed an inhibitory activity of biofilm formation in Klebsiella sp. 1087 (Fig. 4b). In the control, sessile cells alone or grouped within a compact matrix, forming a clear biofilm structure, were observed under SEM (Fig. 4b). However, when the strain grew in contact with LF, its capacity to form biofilm was notably reduced, since only a few cells were attached to the glass and, in some cases, they were elongated and their external structure was modified (Fig. 4b).
Finally, we decided to quantify the anti-biofilm effect of LF at 9 mg/mL against E. coli ATCC 25,922, E. coli 4591, Klebsiella sp. 1101, and Klebsiella sp. 1087 (Table 1) by CV assay after 24-h treatment. The obtained measures allowed us to classify both E. coli strains as strong biofilm formers (Table 1). However, after contact with LF, CV absorbance values were drastically reduced and both strains became weak biofilm formers (Table 1). The strains Klebsiella sp. 1087 and 1101 showed moderate and strong biofilm-forming capacity under normal conditions, respectively (Table 1). As found for E. coli, Klebsiella sp. was affected by LF activity, with both strains showing a reduced capacity to form biofilm (Table 1).
UV-MALDI-MS analysis of lipopeptides produced by B. licheniformis B6
Production of cyclic lipopeptide compounds by B. licheniformis B6 was analyzed by UV-MALDI-MS. Mass spectra of CFS (Fig. S1a) and LF (Fig. S1b) revealed mass peaks ranging from m/z 850 to m/z 1200 Da (Fig. S1), assigned to the isoforms of kurstakins, surfactins, and iturins ranging from m/z 1300 and m/z 1650 Da (Fig. S2), which can be assigned to fengycins and bacitracins using data from the literature (Vater et al. 2002; Price et al. 2007; Pecci et al. 2010; Pathak et al. 2012) and MS/MS analysis (see below). The particular mass peaks obtained in CFS and LF are listed with their corresponding lipopeptide family (Table 2). Peaks at m/z 988.2, m/z 1001.7, m/z 1015.5, m/z 1030.6, m/z 1044.5, and m/z 1058.3 were detected in both samples. They revealed differences of 14 m/z units, suggesting a series of homologous molecules with different lengths of fatty acid chains (i.e., CH2 = 14 Da). Those peaks were assigned as a sodiated adduct of surfactin with fatty acid chain lengths of C10-C15 (Table 2). C15 surfactin was additionally found as a potasiated adduct at m/z 1074.4. Surfactin homologues were the most intense signals of all homologues in the spectra. Moreover, homologues observed at m/z = 1052.4 (CFS), m/z 1066.6 (CFS), m/z 1080.4 (CFS and LF), and m/z 1096.3 (CFS and LF) were assigned to bacillomycin D or iturin A homologues (Table 2). Additionally, kurstakin homologues (C10-C12 and C16) were registered as sodiated adducts at m/z 888.4 (LF), m/z 902.4 (LF), m/z 916.9 (CFS and LF), and m/z 970.7 (CFS). Mass spectra of CFS (Fig. S1a) and LF (Fig. S1b) were similar in the 900-1,200 Da range, the region where kurstakins, surfactins, and iturins (or bacillomycin) homologues were detected. The total number of signals observed for CFS and LF samples was very similar (Fig. S1), yet, the relative intensity of peaks at m/z 1074 and m/z 1080 was different in LF in relation to CFS. However, the number and relative intensity of fengycin homologues found in both samples were completely different, demonstrating that recovery of fengycin homologues was more efficient in LF compared to CFS (Fig. S2b).
Homologues of fengycin A were detected in the CFS sample at m/z 1450.9 (C15 [M + H]+), m/z 1464.6 (C16 [M + H]+), m/z 1480.4 (C16 [M + Na]+), m/z 1494.4 (C17 [M + Na]+), and m/z 1515.7 (C17 [M + K]+). In addition, sodiated adducts of fengycin B were observed at m/z 1508.9 and 1536.9 (C16 and C17, respectively) (Fig. S2a). Moreover, protonated adducts of bacitracin C were observed at m/z 1392.5, and protonated and sodiated adducts of bacitracin A were registered at m/z 1421.2 and m/z 1443.7, respectively. Fig. S2b shows mass spectra of LF. Peaks were assigned as bacitracin A (m/z 1422.26 [M + H]+), fengycin A (m/z 1449.6 (C15 [M + H]+), m/z 1467.9 (C15 [M + Na]+) and m/z 1495.8 (C17 [M + Na]+), fengycin B (m/z 1476.7 (C16 [M + H]+), m/z 1506.6 (C17 [M + H]+), m/z 1524.3 (C17 [M + Na]+), m/z 1540.5 (C17 [M + K]+), and m/z 1556.16 (C18 [M + K]+). For structural characterization of lipopeptides, UV-MALDI-TOF MS/MS (Laser-Induced fragmentation/Decomposition, LID) was performed (Fig. S3-S6). Fig. S3 shows the MS/MS spectrum of the precursor ion [M + Na]+ ion detected at m/z = 1031.49 in LF fraction of B6. The fragmentation of the precursor ion yielded ions at m/z 916.91 (ion 3, Fig. S3), m/z 803.83 (ion 4, Fig. S3), and m/z 688.79 (ion 7, Fig. S3). These fragments correspond to the sequential losses of the amino acid residues of L, L, and D (Scheme1, Table S1). Moreover, fragment ions that represent characteristic marker ions for identification of surfactins were found (Fig. S3) (Ma et al. 2016, Torres et al. 2015). For instance, peaks at m/z = 685.74 [y6 + H2O + H]+, m/z = 594.55 [y5 + H2O + Na]+, and m/z = 481.43 [y4 + H2O + Na]+ were detected (Fig.S3). In addition, fragmentation of the chain side of the amino acids was also observed. For instance, loss of COOH moiety (44 Da) (ion 1, Fig. S3) and of CH2CH2COOH moiety from glutamic acid (72 Da) (ions 2 and 6, Fig. S3) was also detected in the spectrum shown in Fig. S3. The sequence was then determined from the fragmentation profile as β-OH fatty acid-E- L-L-V-D-L-L/I.
Similarly, Fig. S4 shows the MS/MS spectrum of the precursor ion [M + Na]+ ion detected at m/z = 1059.11 in LF fraction of B6. Its fragmentation yielded ions at m/z 946.29 (ion 3, Fig. S4), m/z 833.13 (ion 4, Fig. S4), m/z 717.00 (ion 7, Fig. S4), and m/z 618.76 (ion 8, Fig. S4). These fragments correspond to the sequential losses of the amino acid residues of L, L, D, and V. Moreover, fragment ions that represent characteristic marker ions for identification of surfactins were observed, as shown in Fig. S4, Table S2 (Ma et al. 2016, Torres et al. 2015). For instance, peaks at m/z = 595.68 [y5 + H2O + Na]+, m/z = 572.74 [y5 + H2O + H]+, m/z = 482.44 [y4 + H2O + Na]+, m/z = 459.49 [y4 + H2O + H]+, and m/z = 268.03 [y2 + H2O + Na]+ were registered. Fragmentation of the chain side of the amino acids was also observed (Fig. S4). Then the sequence was determined from the fragmentation profile as β-OH fatty acid-E- L-L-V-D-L-L/I.
Moreover, the MS/MS spectrum of the precursor ion [M + H]+= 1477.85 was measured (Fig. S5). The complex pattern shown by the precursor ion m/z region (Fig. S5 inset) suggests that a mixture of precursors with [M + H]+ values between m/z 1465 and m/z 1480 contributes to the MS/MS spectrum. Diagnosis signals of fengycin B2 homologue (Lin et al. 2020) were observed in the MS/MS spectrum when the peptide bond between Y3 and T4 was broken (Scheme 2, Table S3) at m/z = 1094.21 (y9 + H+), m/z = 1077.13 (y9-H2O + H+), m/z = 980.04 (y8 + H+) and m/z = 739.00 (y6 + Na+) (Fig. S5). Additionally, signals at m/z = 1252.71 (b6 + H+) and m/z = 226.00 (y2 + H+) were registered when the peptide bond between P7 and V6 was broken (Scheme 3, Table S3). Then the sequence was determined from the fragmentation profile as E1-O2-Y3-T4-E5-V6-P7-Q8-Y9-V10 with a C16 β-OH fatty acid.
The MS/MS spectrum of the precursor ion [M + H]+=1505.95 is shown in Fig. S6. Diagnosis signals of fengycin B homologue were observed in the MS/MS spectrum when the peptide bond between Y3 and T4 was broken (Scheme 4, Table S4) at m/z = 1238.98 (y10 + H+), m/z = 1108.90 (y9 + H+), and m/z = 997.05 (y8 + H+). Moreover, signal at m/z = 1279.81 (b6 + H+) was found when the peptide bond between P7 and V6 was broken (Scheme 5, Table S4). Then the sequence was deduced from the fragmentation profile as E1-O2-Y3-T4-E5-V6-P7-Q8-Y9-I10 with a C17 β-OH fatty acid.
Discussion
In recent years, the resistance to antibiotics developed by bacteria has posed risks to the prevention and treatment of bacterial infections. Due to this highly severe increase, in 2018, a report published by the World Health Organization (WHO) included Klebsiella sp., E. coli, and S. aureus in a group of eight priority pathogenic bacteria of human health significance, since they cause hospital- and/or community-acquired infections, generating high economic costs to public health. In 2021, the WHO informed that the search for new antibiotics to control these drug-resistant infections continues and addressed the need for urgent solutions. Accordingly, different approaches are being developed to treat this global problem.
In this work, we analyzed the antagonistic activity of a bacterial strain isolated from an artisanal tannery located in Salta, Argentina, and phylogenetically characterized as Bacillus licheniformis B6, against E. coli, Klebsiella sp. and, S. aureus. This bacterial species can synthesize bioactive compounds, such as enzymes, lipopeptides, and bacteriocins (Berić et al. 2014; Lawrance et al. 2014; Muslim et al. 2016). In particular, lipopeptides are compounds known for their wide spectrum of antagonistic activity against pathogenic bacteria (Rivardo et al. 2011; Chen et al. 2012; Chen and Yu 2020). Such inhibitory spectrum would be specific to each B. licheniformis strain. Hence, the strain B. licheniformis P40 isolated from the Amazon basin was found to inhibit Listeria monocytogenes, Bacillus cereus, and clinical isolates of Streptococcus sp.; yet, it did not produce activity against S. aureus (Cladera Olivera et al. 2004). Shobharani et al. (2015) studied two isolates of B. licheniformis, MCC2514, and MCC2512, from sheep milk and rhizospheric soil; authors found that the antimicrobial compounds of these strains had inhibitory activity against Micrococcus luteus, S. aureus, Klebsiella sp., and Aeromonas hydrophila, although they tested only one strain of each species. In addition, they reported that the inhibitory activity of both B. licheniformis strains differed, since MCC2512 also inhibited L. monocytogenes and Salmonella Typhimurium. On the other hand, B. licheniformis M104, isolated from soil samples, reduced the viability of S. aureus ATCC25918 and two strains of E. coli, ATCC11775 and ATCC11246 (Gomaa 2012).
Here, we found that the lipopeptide fraction (LF) of B. licheniformis B6 had inhibitory capacity against S. aureus, E. coli, and Klebsiella sp. This antibacterial activity was achieved by incubating the B6 strain for 6 days, a period in which the maximum production of lipopeptides is obtained (Díaz, 2017). Note that LF reduced growth of E. coli 4591, a clinical strain with high resistance to antibiotics. This pathogenic strain was sensitive at 250 mg/mL of ampicillin onwards, whereas at 9 mg/mL of B6 LF, an inhibitory effect on viability was seen. In addition, both strains of Klebsiella sp. showed sensitivity to antibacterial activity of lipopeptides synthesized by B6. On the other hand, the studied strains of S. aureus revealed a differential sensitivity to LF: ATCC43300 was resistant at 9 mg/mL of LF compared to the high sensitivity shown by strain 269. These results reveal that the antibacterial effect of B. licheniformis B6 lipopeptides is strain-dependent. Therefore, it is necessary to study more than one strain per bacterial genus to report the “real” inhibitory capacity of a biometabolite. Thus, if only a single strain of each genus or species is analyzed, results may be inconclusive, not fully reliable and difficult to reproduce (Audisio et al. 2005).
Biofilm formation during bacterial infection poses an additional problem to natural resistance, since it is a mechanism that does not allow bacteria to be easily eradicated using conventional antibiotics (Høiby et al. 2010; Birarda et al. 2019). It is estimated that about 65% of all bacterial infections are associated with biofilm formation (WHO 2018). As a result, various biological alternatives for treating bacterial biofilms have been investigated, and biosurfactants have gained particular attention. In this work, we demonstrated that 9 mg/mL of a LF synthesized by B. licheniformis B6 significantly reduced biofilm formation by cells of E. coli and Klebsiella sp. This effect can be due to the capacity of lipopeptides to modify bacterial surface hydrophobicity, to affect development of flagella, and to interfere with cell adherence to glass, plastic, and tissue surfaces (Rivardo et al. 2011; Moryl et al. 2015; Chen et al. 2017). These results agree with those showing a great anti-biofilm potential of lipopeptides. For example, Giri et al. (2019) reported that a 1.5 mg/mL concentration of lipopeptides produced an anti-biofilm effect on Sal. Typhimurium and S. aureus. Another work described the inhibition of adherence of E. coli CFT073 and S. aureus ATCC 29,213 to polystyrene surfaces induced by lipopeptides synthesized by B. subtilis and B. licheniformis (Rivardo et al. 2011). The present results contribute to the growing need for new antimicrobial compounds with anti-biofilm activity, since it has been demonstrated that the minimum inhibitory concentration (MIC) and minimum bacterial concentration (MBC) of synthetic antibiotics used against bacteria that grow in biofilms can be up to 100-1,000 times higher than those of planktonic bacteria (Høiby et al. 2010; Donelli and Vuotto 2014). Using UV- MALDI TOF mass spectrometry, we found signals corresponding to kustakins, surfactins, and iturins within a 900-1,200 Da range, and bacitracins and fengycins within a 1,300-1,600 Da range in the CFS and LF of B. licheniformis B6; surfactin was the lipopeptide with the highest intensity in the mass spectra. According to the literature, some strains of B. licheniformis produced lichenysins and were mostly detected as sodium adducts at m/z 1029 and 1057 Da (Joshi et al. 2015; Suthar and Nerurkar 2016). Our results contrast those findings: when signals of m/z 1031.49 and m/z 1059.11 were fragmented, fragment ions representing characteristic markers for identification of surfactins were seen (Torres et al. 2015). Therefore, our MSMS results demonstrated that B6 produced mostly surfactins, rather than lichenysins, in agreement with findings reported by Pecci et al. (2010). Surfactin causes cell lysis, mainly in Gram-positive bacteria (He and Chen 2006). This lipopeptide can destabilize lipid packing and form pores in biological membranes. It can also penetrate the membrane through hydrophobic interactions, thus influencing the ordering of the hydrocarbon chain and varying membrane thickness (Carrillo et al. 2003). The second most intense signals corresponded to the family of fengycins. Although they show activity against filamentous fungi, their antibacterial efficacy against Gram-positive and Gram-negative pathogens was also demonstrated (Hu et al. 2007; Torres et al. 2016; Lin et al. 2020).
The fragmentation and diagnosis of the complex pattern of signals at m/z 1476.71 as [M + H] + and m/z 1505.95 as [M + H] + confirmed their identity as fengycins A and B, respectively, as reported by (Lin et al. 2020). This surfactant acts by forming pores, leading to changes in membrane permeability (Deleu et al. 2005); it may alter or modify the alignment of the phospholipid acyl chain and globally decrease the cooperativity of the lipid–lipid and lipid–fengycin interaction in the bilayer membrane (Deleu et al. 2008). Another lipopeptide found in LF by UV- MALDI TOF corresponds to bacitracin A, with an m/z 1422.75 as [M + H]+. The production of this dodecapeptide by B. licheniformis was early demonstrated by Bernlohrl and Novell (1960). It should be noted that its synthesis is rare in other species of the genus Bacillus, which shows the importance of its detection in the LF of B. licheniformis B6. This antibiotic can inhibit the synthesis of the cell wall of most Gram-positive and some Gram-negative bacteria. Moreover, it has a rapid excretion rate and low absorption, which allows its use in the food industry as an additive for animal feed (Cai et al. 2020). Lipopeptides synthesized by B. licheniformis B6 might be acting synergistically against the pathogenic bacteria analyzed in this work, which explains their potential in the reduction of viability and biofilm formation of bacteria s of clinical importance, such as E. coli, Klebsiella sp., and S. aureus. However, further studies including biofilm-forming multi-drug-resistant (MDR) strains, of medical interest found in nosocomial infections (Birarda et al. 2019), are required.
Conclusion
The results of this work show that lipopeptides synthesized by B. licheniformis B6 have potential antibacterial and anti-biofilm activity against pathogenic bacteria of health importance. Therefore, they may be considered an alternative for the biocontrol of these pathogens. Further in-depth studies of the structure, administration dose, and toxicity of these compounds should be conducted for their future application.
References
Audisio MC, Terzolo HR, Apella MC (2005) Bacteriocin from honeybee beebread Enterococcus avium, active against Listeria monocytogenes. Appl Environ Microbiol 71:3373–3375. https://doi.org/10.1128/AEM.71.6.3373-3375.2005
Berić T, Stanković S, Draganić V et al (2014) Novel antilisterial bacteriocin licheniocin 50.2 from Bacillus licheniformis VPS50.2 isolated from soil sample. J Appl Microbiol 116:502–510. https://doi.org/10.1111/jam.12393
Bernlohrl W, Novell GD (1960) Some characteristics of bacitracin production by Bacillus licheniformis. Arch Biochem Biophys 87:232–238
Birarda G, Delneri A, Lagatolla C et al (2019) Multi-technique microscopy investigation on bacterial biofilm matrices: a study on Klebsiella pneumoniae clinical strains. Anal Bioanal Chem. https://doi.org/10.1007/s00216-019-02111-7
Bonmatin J-M, Laprevote O, Peypoux F (2012) Diversity Among Microbial Cyclic Lipopeptides: Iturins and Surfactins. Activity-Structure Relationships to Design New Bioactive Agents. Comb Chem High Throughput Screen 6:541–556. https://doi.org/10.2174/138620703106298716
Borucki MK, Peppin JD, White D et al (2003) Variation in Biofilm Formation among Strains of Listeria monocytogenes. Appl Environ Microbiol 69:7336–7342. https://doi.org/10.1128/AEM.69.12.7336-7342.2003
Cai D, Zhang B, Zhu J et al (2020) Enhanced Bacitracin Production by Systematically Engineering S-Adenosylmethionine Supply Modules in Bacillus licheniformis. 8:1–12. https://doi.org/10.3389/fbioe.2020.00305
Carrillo C, Teruel A, Aranda FJ, Ortiz A (2003) Molecular mechanism of membrane permeabilization by the peptide antibiotic surfactin. 1611:91–97. https://doi.org/10.1016/S0005-2736(03)00029-4
Chen Y, Liu SA, Mou H et al (2017) Characterization of lipopeptide biosurfactants produced by Bacillus licheniformis MB01 from marine sediments. Front Microbiol 8:1–11. https://doi.org/10.3389/fmicb.2017.00871
Chen YC, Chiang TJ, Liang TW et al (2012) Reclamation of squid pen by Bacillus licheniformis TKU004 for the production of thermally stable and antimicrobial biosurfactant. Biocatal Agric Biotechnol 1:62–69. https://doi.org/10.1016/j.bcab.2011.08.010
Chen YC, Yu YH (2020) Bacillus licheniformis-fermented products improve growth performance and the fecal microbiota community in broilers. Poult Sci 99:1432–1443. https://doi.org/10.1016/j.psj.2019.10.061
Cladera-Olivera F, Caron GR, Brandelli A (2004) Bacteriocin-like substance production by Bacillus licheniformis strain P40. Lett Appl Microbiol 38:251–256. https://doi.org/10.1111/j.1472-765X.2004.01478.x
Deleu M, Paquot M, Nylander T (2005) Fengycin interaction with lipid monolayers at the air – aqueous interface — implications for the effect of fengycin on biological membranes. 283:358–365. https://doi.org/10.1016/j.jcis.2004.09.036
Deleu M, Paquot M, Nylander T (2008) Effect of Fengycin, a Lipopeptide Produced by Bacillus subtilis, on Model Biomembranes. Biophys J 94:2667–2679. https://doi.org/10.1529/biophysj.107.114090
Desai JD, Banat IM (1997) Microbial production of surfactants and their commercial potential. Microbiol Mol Biol Rev 61:47–64. https://doi.org/10.1128/mmbr.61.1.47-64.1997
Donelli G, Vuotto C (2014) Biofilm-based infections in long-term care facilities. Future Microbiol 9:175–188. https://doi.org/10.2217/fmb.13.149
EFSA (2021) Safety and efficacy of the feed additive consisting of Bacillus licheniformis DSM 28710 (B-Act®) for laying hens, minor poultry species for laying, poultry species for breeding purposes and ornamental birds (HuvePharma N.V.). EFSA J 19. https://doi.org/10.2903/j.efsa.2021.6449
FAO (2011) 74th JECFA - Chemical and Technical Assessment (CTA), 2011 © FAO 2011. 1–6
Flemming HC, Wingender J, Szewzyk U et al (2016) Biofilms: An emergent form of bacterial life. Nat Rev Microbiol 14:563–575. https://doi.org/10.1038/nrmicro.2016.94
Fux CA, Costerton JW, Stewart PS, Stoodley P (2005) Survival strategies of infectious biofilms. Trends Microbiol 13:34–40. https://doi.org/10.1016/j.tim.2004.11.010
Giri SS, Ryu EC, Sukumaran V, Park SC (2019) Antioxidant, antibacterial, and anti-adhesive activities of biosurfactants isolated from Bacillus strains. Microb Pathog 132:66–72. https://doi.org/10.1016/j.micpath.2019.04.035
Gomaa EZ (2012) Antimicrobial activity of a biosurfactant produced by Bacillus licheniformis strain M104 grown on whey. 6:4396–4403. https://doi.org/10.5897/AJMR11.463
He L, Chen W (2006) Synergetic activity of nisin with cell-free supernatant of Bacillus licheniformis ZJU12 against food-borne bacteria. Food Res Int 39:905–909. https://doi.org/10.1016/j.foodres.2006.05.008
Høiby N, Bjarnsholt T, Givskov M et al (2010) Antibiotic resistance of bacterial biofilms. Int J Antimicrob Agents 35:322–332. https://doi.org/10.1016/j.ijantimicag.2009.12.011
Hu L, Bin, Shi ZQ, Zhang T, Yang ZM (2007) Fengycin antibiotics isolated from B-FS01 culture inhibit the growth of Fusarium moniliforme Sheldon ATCC 38932. FEMS Microbiol Lett 272:91–98. https://doi.org/10.1111/j.1574-6968.2007.00743.x
Ibarguren C, Vivas L, Alejandra Bertuzzi M et al (2010) Edible films with anti-Listeria monocytogenes activity. Int J Food Sci Technol 45:1443–1449. https://doi.org/10.1111/j.1365-2621.2010.02286.x
Joshi SJ, Geetha SJ, Desai AJ (2015) Characterization and Application of Biosurfactant Produced by Bacillus licheniformis R2. 346–361. https://doi.org/10.1007/s12010-015-1746-4
Lautenbach E, Patel JB, Bilker WB et al (2001) Extended spectrum beta lactamase producing Escherichia coli and Klebsiella pneumoniae: Risk factors for infection and impact of resistance on outcomes. J Assoc Physicians India 58:41–44
Lawrance A, Balakrishnan M, Cheriath T et al (2014) Functional and molecular characterization of a lipopeptide surfactant from the marine sponge-associated eubacteria Bacillus licheniformis NIOT-AMKV06 of Andaman and Nicobar Islands, India. Mar Pollut Bull 82:76–85. https://doi.org/10.1016/j.marpolbul.2014.03.018
Lin J, Lin L, Zheng Q et al (2020) Isolation and Characterization of Fengycins Produced by Bacillus amyloliquefaciens JFL21 and Its Broad-Spectrum Antimicrobial Potential Against Multidrug-Resistant Foodborne Pathogens. 11. https://doi.org/10.3389/fmicb.2020.579621
Lin LL, Chyau CC, Hsu WH (1998) Production and properties of a raw-starch-degrading amylase from the thermophilic and alkaliphilic Bacillus sp. TS-23. Biotechnol Appl Biochem 28:61–68. https://doi.org/10.1111/j.1470-8744.1998.tb00513.x
Merritt JH, Kadour DE, O’Toole GA (1947) Gold therapy at the Arthritis Clinic, Boston Dispensary. Bull New Engl Med Cent 9:248–254. https://doi.org/10.1002/9780471729259.mc01b01s00.Growing
Moryl M, Spętana M, Dziubek K et al (2015) Antimicrobial, antiadhesive and antibiofilm potential of lipopeptides synthesised by Bacillus subtilis, on uropathogenic bacteria Acta Biochim Pol. 62:725–732. https://doi.org/10.18388/abp.2015_1120
Muslim SN, AL-Kadmy IMS, Hussein NH et al (2016) Chitosanase purified from bacterial isolate Bacillus licheniformis of ruined vegetables displays broad spectrum biofilm inhibition. Microb Pathog 100:257–262. https://doi.org/10.1016/j.micpath.2016.10.001
Newell DG, Koopmans M, Verhoef L et al (2010) Food-borne diseases - The challenges of 20years ago still persist while new ones continue to emerge. Int J Food Microbiol 139. https://doi.org/10.1016/j.ijfoodmicro.2010.01.021
O’Toole GA, Kolter R (1998) Initiation of biofilm formation in Pseudomonas fluorescens WCS365 proceeds via multiple, convergent signalling pathways: A genetic analysis. Mol Microbiol 28:449–461. https://doi.org/10.1046/j.1365-2958.1998.00797.x
Pathak KV, Keharia H, Gupta K et al (2012) Lipopeptides from the banyan endophyte, Bacillus subtilis K1: Mass spectrometric characterization of a library of fengycins. J Am Soc Mass Spectrom 23:1716–1728. https://doi.org/10.1007/s13361-012-0437-4
Pecci Y, Rivardo F, Martinotti MG, Allegrone G (2010) LC/ESI-MS/MS characterisation of lipopeptide biosurfactants produced by the Bacillus licheniformis V9T14 strain. J Mass Spectrom 45:772–778. https://doi.org/10.1002/jms.1767
Price NPJ, Rooney AP, Swezey JL et al (2007) Mass spectrometric analysis of lipopeptides from Bacillus strains isolated from diverse geographical locations. FEMS Microbiol Lett 271:83–89. https://doi.org/10.1111/j.1574-6968.2007.00702.x
Ramasubburayan R, Titus S, Verma PK et al (2014) Isolation, screening and optimization of culture conditions for enhanced antibacterial activity by a marine epibiotic bacterium Bacillus flexus APGI against fouling bacterial strains. J Pure Appl Microbiol 8:2909–2920
Rivardo F, Martinotti MG, Turner RJ, Ceri H (2011) Synergistic effect of lipopeptide biosurfactant with antibiotics against Escherichia coli CFT073 biofilm. Int J Antimicrob Agents 37:324–331. https://doi.org/10.1016/j.ijantimicag.2010.12.011
Sabaté DC, Carrillo L, Audisio MC (2009) Inhibition of Paenibacillus larvae and Ascosphaera apis by Bacillus subtilis isolated from honeybee gut and honey samples. Res Microbiol 160:193–199. https://doi.org/10.1016/j.resmic.2009.03.002
Sabaté DC, Gonzaléz MJ, Porrini MP et al (2012) Synergistic effect of surfactin from Bacillus subtilis C4 and Achyrocline satureioides extracts on the viability of Paenibacillus larvae. World J Microbiol Biotechnol 28:1415–1422. https://doi.org/10.1007/s11274-011-0941-x
Shobharani P, Padmaja RJ, Halami PM (2015) Diversity in the antibacterial potential of probiotic cultures Bacillus licheniformis MCC2514 and Bacillus licheniformis MCC2512. Res Microbiol 166:546–554. https://doi.org/10.1016/j.resmic.2015.06.003
Stepanović S, Ćirković I, Ranin L, Švabić-Vlahović M (2004) Biofilm formation by Salmonella spp. and Listeria monocytogenes on plastic surface. Lett Appl Microbiol 38:428–432. https://doi.org/10.1111/j.1472-765X.2004.01513.x
Suthar H, Nerurkar A (2016) Characterization of Biosurfactant Produced by Bacillus licheniformis TT42 Having Potential for Enhanced Oil Recovery. Appl Biochem Biotechnol 248–260. https://doi.org/10.1007/s12010-016-2096-6
Torres MJ, Brandan CP, Petroselli G et al (2016) Antagonistic effects of Bacillus subtilis subsp. subtilis and B. amyloliquefaciens against Macrophomina phaseolina: SEM study of fungal changes and UV-MALDI-TOF MS analysis of their bioactive compounds. Microbiol Res 182:31–39. https://doi.org/10.1016/j.micres.2015.09.005
Torres MJ, Petroselli G, Audisio MC et al (2015) Bacillus subtilis subsp. subtilis CBMDC3f with antimicrobial activity against Gram-positive foodborne pathogenic bacteria: UV-MALDI-TOF MS analysis of its bioactive compounds. World J Microbiol Biotechnol 929–940. https://doi.org/10.1007/s11274-015-1847-9
Van Houdt R, Michiels CW (2010) Biofilm formation and the food industry, a focus on the bacterial outer surface. J Appl Microbiol 109:1117–1131. https://doi.org/10.1111/j.1365-2672.2010.04756.x
Vater J, Kablitz B, Wilde C et al (2002) Matrix-assisted laser desorption ionization-time of flight mass spectrometry of lipopeptide biosurfactants in whole cells and culture filtrates of Bacillus subtilis C-1 isolated from petroleum sludge. Appl Environ Microbiol 68:6210–6219. https://doi.org/10.1128/AEM.68.12.6210-6219.2002
Youssef NH, Duncan KE, Nagle DP et al (2004) Comparison of methods to detect biosurfactant production by diverse microorganisms. J Microbiol Methods 56:339–347. https://doi.org/10.1016/j.mimet.2003.11.001
Zhao H, Shao D, Jiang C et al (2017) Biological activity of lipopeptides from Bacillus. Appl Microbiol Biotechnol 101:5951–5960. https://doi.org/10.1007/s00253-017-8396-0
Zhao H, Shao D, Jiang C, et al (2017) Biological activity of lipopeptides from Bacillus. Appl Microbiol Biotechnol 101:5951–5960. https://doi.org/10.1007/s00253-017-8396-0
Acknowledgements
This work was supported by funds from the University of Buenos Aires (Argentina; UBACyT 20020170100110BA), and the Agencia Nacional de Promoción Científica y Tecnológica (ANPCYT) (Argentina, PICT2016-00130; PICT2015-00640). The Ultraflex II TOF/TOF mass spectrometer (Bruker Daltonics) was supported by a grant from ANPCYT (PME2003 No.125, CEQUIBIEM, DQB, FCEN, University of Buenos Aires). Audisio M.C., Erra-Basells R., Petroselli G. and Torres M.J. are Research Members at Consejo Nacional de Investigaciones Científicas y Tecnológicas (CONICET, Argentina). Díaz P.R. was supported by doctoral fellowships from ANPCyT and CONICET (Argentina).
Author information
Authors and Affiliations
Corresponding author
Ethics declarations
Conflict of interest
We declare no competing interests.
Additional information
Publisher’s Note
Springer Nature remains neutral with regard to jurisdictional claims in published maps and institutional affiliations.
Electronic supplementary material
Below is the link to the electronic supplementary material.
Rights and permissions
Springer Nature or its licensor holds exclusive rights to this article under a publishing agreement with the author(s) or other rightsholder(s); author self-archiving of the accepted manuscript version of this article is solely governed by the terms of such publishing agreement and applicable law.
About this article
Cite this article
Díaz, P.R., Torres, M.J., Petroselli, G. et al. Antibacterial activity of Bacillus licheniformis B6 against viability and biofilm formation of foodborne pathogens of health importance. World J Microbiol Biotechnol 38, 181 (2022). https://doi.org/10.1007/s11274-022-03377-3
Received:
Accepted:
Published:
DOI: https://doi.org/10.1007/s11274-022-03377-3